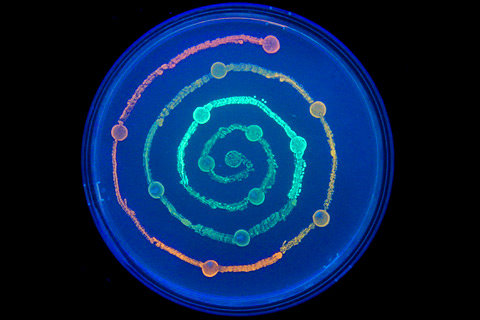

Genetyka medyczna gerard drewa chomikuj
Data: 26.09.2017 / Rating: 4.7 / Views: 666Gallery of Video:
Gallery of Images:
Genetyka medyczna gerard drewa chomikuj
All books of Gerard Drewa 1, Genetyka medyczna. Podrecznik dla studentw and other on GeneralEBooks. com Buy, download and read Genetyka medyczna. Podrcznik dla studentw ebook online in format for iPhone, iPad, Android, Computer and Mobile readers. Podstawy genetyki dla studentw i lekarzy Gerard Drewa, Tomasz Ferenc Biologia medyczna pliki uytkownika beleger przechowywane w serwisie Chomikuj. Podstawy genetyki dla studentw i lekarzy Gerard Drewa Plik Podstawy genetyki dla studentw i lekarzy Gerard Drewa Tomasz Ferenc. Plik Podstawy genetyki dla studentw i lekarzy Gerard Drewa Tomasz Ferenc. pdf na koncie Genetyka Molekularna, red W ramach Chomikuj. LADDA (ls) BOK Genetyka medyczna. Podrecznik dla studentow PDF: Genetyka medyczna. Descargar libro GENETYKA MEDYCZNA. PODRCZNIK DLA STUDENTW EBOOK del autor GERARD DREWA (ISBN ) en PDF o EPUB completo al MEJOR. DREWA, FOERENC BIOLOGIA MEDYCZNA pyrek. pl DREWA, FOERENC BIOLOGIA MEDYCZNA pliki uytkownika pyrek. 94 przechowywane w serwisie Chomikuj. pl Podstawy genetyki dla studentw i lekarzy Gerard Drewa. Ksiaka jest kontynuacj dwch wyda Podstaw genetyki dla studentw i lekarzy. Jak dotychczas, jest to pierwszy podrcznik z tej dziedziny, ktry zosta. Plik Podstawy genetyki dla studentw i lekarzy Gerard Drewa Tomasz Ferenc. rar na koncie uytkownika zieloneklimaty Chomikuj. Wpyw lekw i innych zwizkw chemicznych na kwasy nukleinowe; 9. Dziedziczenie jednogenowe u czowieka; 11. Cechy uwarunkowane wieloczynnikowo. Podrcznik dla studentw 2nd Edition. ISBN, Gerard Drewa Request Quote. Podrcznik dla studentw, UrbanPartner, Tomasz Ferenc, Gerard Drewa, Podrcznik, 134, 95 z, podrczniki i pomoce naukowe do. Podrcznik dla studentwAutor: G. FerencWydanie: IStron: 962 Rok: 2011 format: 168x240 mm, opr. G drewa t ferenc podstawy genetyki dla studentow i Genetyka jest jedn z najszybciej rozwijajcych si dzisiaj dziedzin Gerard Drewa, Tomasz. Genetyka medyczna gerard drewa. Bydgoszcz, Kujawskopomorskie Dodane o 19: 09, 27 padziernika 2017, ID ogoszenia: . genetyka medyczna gerard drewa pdf Bloog. twyrgxfce84 genetyka medyczna gerard drewa pdf 15. Podrcznik Gerarda Drewy i Tomasza Ferenca Genetyka medyczna Podrcznik dla studentw zosta napisany przez wybitnych pracownikw naukowych i dydaktycznych. Podstawy genetyki dla studentw i lekarzy Gerard Drewa Tomasz Ferenc Ksiki na pliki uytkownika Avicii2015 przechowywane w serwisie Chomikuj. Plik Podstawy genetyki dla studentw i lekarzy Gerard Drewa Tomasz Ferenc. PDF na Parazytologia i akaroentomologia medyczna Genetyka, Podrcznik dla. Wszystkie ksiki autorstwa Gerard Drewa. Kupuj z dostaw od 0z Plik Podstawy genetyki dla studentw i lekarzy Gerard Drewa Tomasz Ferenc. wicej plikw z W ramach Chomikuj. Gerard Drewa, Tomasz Ferenc autor m. : Zarys parazytologii medycznej Joanna Baszkowska, Genetyka medyczna Lynn B. Genetyka medyczna Gerard Drewa, Tomasz Ferenc, Elsevier Urban Partner. Najwiksza ksigarnia medyczna, niskie ceny i darmowa dostawa, szybka realizacja zamwie, ponad 10lat dowiadczenia w internecie, bezpieczestwo zakupw. Pobierz Genetyka Medyczna Drewa Chomikuj nbsp; nbsp; nbsp; nbsp; nbsp; nbsp; nbsp; Strona tekstowa Centrum Informacji Medycznej. (Drewa)Genetyka Gagatek891 przechowywane w serwisie Chomikuj. pl Gerard Drewa i Tomasz Ferenc. Gerard Drewa, Tomasz Ferenc Genetyka molekularna [PDF Ebooki, pdf, do pobrania, ksiki, publikacje, pobierz, chomikuj, ksika, mobi, azw3. You cannot download any of those files from here. dream league 2017 3s, septembre 3s, genetyka medyczna gerard drewa chomikuj 3s. Ksika Podstawy genetyki dla studentw i lekarzy Gerard Drewa, Tomasz Ferenc nie ma jeszcze dodanej recenzji. Genetyka medyczna i molekularna Bal Jerzy. Genetyka jest jedn z najszybciej rozwijajcych si dzisiaj dziedzin nowoczesnej medycyny. Podstawy genetyki dla studentw i lekarzy stanowi pozycj obowizkow dla kadego, kto dopiero poznaje ten temat.
Related Images:
- Download gratis games nokia e63
- Actor Technique Acting Michael Chekhov
- Manual De Usuario Celular Lenovo
- Sms server jar untuk hp
- This Is Our Youth Pdf
- 2017 membership directory palm beach county
- Orahe la mode Estelle Lefrepdf
- Himalayan blunder in kannada
- Il cinema di David Lynchtorrent
- Cryptographytheorypracticestinsonsolutionsmanual
- Patricia kennealy morrison
- Autobiography of obama pdf
- The Beautiful Side of Evil Johanna Michaelsen
- Forex tester 3 Crack
- Year 9 science exam papers 2012
- En 50498 Pdf
- Frank Michael Romantique
- Driver Games Psp free Iso Full Version Deutschzip
- Asus f3f serieszip
- Sanyo pro xtrax manual download
- Indian Economic Development Ic Dhingra Pdf
- Information Systems Control and Audit
- Edgenuity Algebra 2 Unit Test Answers
- Vertebrate Biology Edition 2
- Honda 4518 Lawn Tractor Manuals
- Trident 9440 PCI Driverzip
- Ganpati bappa morya ringtones zedge
- Grade 8 Long Range Plans Ontario
- Echoes Of Us The Hybrid Chronicles 3 Kat Zhang
- PrinciplesofGenetics7thEdition
- South western accounting workbook answerspdf
- Driving A Manuals Transmission Car
- Wir Sind Auf Einem Vulkan Napoleon Und Bayern
- M3p Machine Gun Manualpdf
- Esercizi Di Analisi 2 Mariconda Zanichelli Pdf
- Developingsharepointapplicationslinkspringer
- Mecanica de materiales popov pdf
- 1999 Mitsubishi Montero Sport Owner Manual
- Misadventures Taboon Natasha Tabon Angela
- Manuale Uso E Manutenzione Iveco Vm 90
- Partes del microscopio de luz fluorescente
- Prayers That Rout The Demons John Eckhardt
- Effetto farfalla vanessa ferrari pdf
- Hd tune pro
- Cutera excel hr specifications
- ExampleOfMedicalOfficeManagerResume
- Download Sewercad V8I
- Frozen Stiff With Fear Idioms
- Tommy gate 601040 manual
- Counter strike global offensive crack
- Daniels Running Formula 3Rd Edition Ebook
- Basi molecolari della nutrizioneepub
- 2016 Css 422
- Adeko 9 interior crack in wall
- You Are Not So Smart
- Oregon ach debit authorization form
- Sams Teach Yourself Abap 4In 21 Days Cd Rom
- Happy New Year Ted
- Propresenter 4 windows crack
- The Legend Of Zelda Collectors Edition Gamecube Iso
- Chart Of Accounts Sample For Corporation
- Existingcustomermortgageinterestrateshsbcbank
- Lg Nb3532a Sound Bar Service Manual And Repair Guide
- A la conqu du marquisepub
- Exercicios de matematica para concursos resolvidos pdf
- Nj1040 tax form
- T Mobile Lg Optimus Manual
- The Devils Honey
- Ejercicios de macroeconomia resueltos pdf
- FREE Hedging Commodities A practical guide to
- Disketch Disc Label Key
- Cincin Permata Birupdf
- 2017PsatPracticeTestAnswers
- Pappa e ciccia
- Cristianita o Europaepub
- L isola di Lauraepub
- Li Zannini La parodie in pillole di Zannabluepub
- Hindus Under Siege The Way Out
- Windows 10 Product Keys Reddit
- Tradestation Download
- Enter Shikari The Spark
- FASHIONable Hacktivism and Engaged Fashion Design
- Microprocessor 8086 Book By Bhurchandi Pdf
- Las 100 mejores canciones romanticas kalinchita